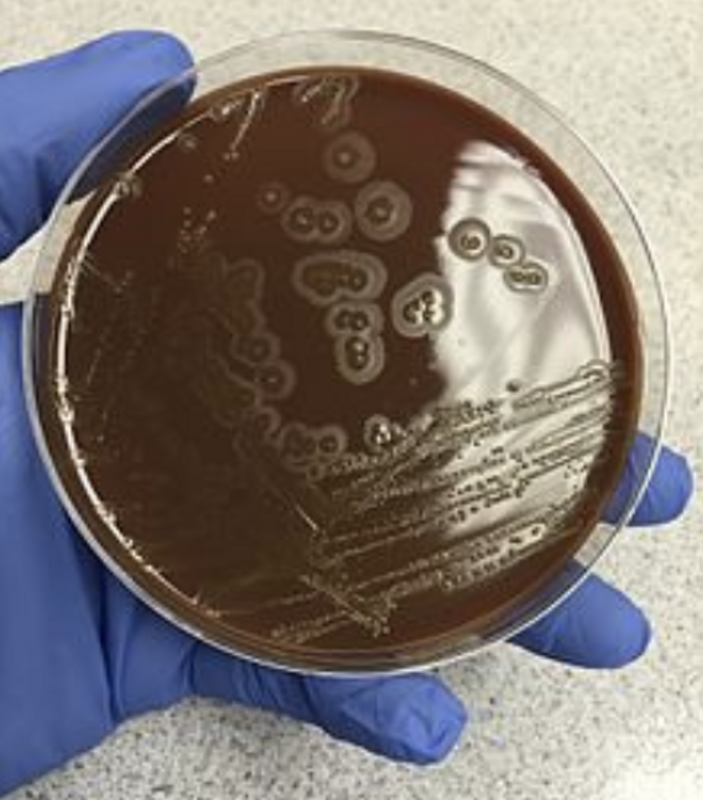
Микроорганизмы HACEK

Акроним "HACEK" широко распространен в клинической микробиологии, хотя его произношение может быть несколько спорным (hay-sek или ha-sek?).
Аббревиатура расшифровывается как Haemophilus, Aggregatibacter, Cardiobacterium, Eikenella и Kingella: все члены HACEK являются прихотливыми грамотрицательными бактериями, ассоциированными с инфекционным эндокардитом.
Группа HACEK основана не на таксономических отношениях, а на склонности организмов вызывать эндокардит. Все организмы HACEK являются комменсалами ротоглотки человека, но как они перемещаются в дистальные отделы, чтобы вызвать заболевание, до конца не установлено. Согласно одной из гипотез, они распространяются гематогенным путем после попадания в кровь во время чистки зубов, стоматологических манипуляций или после заболеваний полости рта, таких как пародонтит.
Большинство эндокардитов вызывается грамположительными бактериями (чаще всего стафилококками или стрептококками), меньшая часть - грамотрицательными бактериями или грибками. Одно из исследований приписало 1,4% случаев эндокардита организмам HACEK. Здесь мы рассмотрим наиболее распространенные виды, входящие в группу HACEK.
Haemophilus parainfluenzae является одним из наиболее распространенных организмов HACEK, ассоциированных с эндокардитом. В отличие от нее, H. influenzae, наиболее известная и наиболее часто выделяемая представительница рода, редко ассоциируется с инфекционным эндокардитом.
H. parainfluenzae была первоначально описана в 1922 году Томасом Риверсом, который выделил ее от больных гриппом. Он дифференцировал ее от H. influenzae на основании ее потребности в NAD (V фактор), но не в гемине (X фактор), в отличие от H. influenzae, которая нуждается в обоих. Риверс первоначально предположил, что эта бактерия является причиной гриппа, хотя сейчас мы знаем, что это заболевание вызывается вирусом гриппа.
Его выделение H. parainfluenzae от больных гриппом, скорее всего, было случайным, так как эта бактерия является комменсалом ротоглотки человека. Она не является причиной таких заболеваний полости рта, как кариес или пародонтит, и преимущественно выделяется из зубного налета со здоровых зубов. Вне ротовой полости H. parainfluenzae способна вызывать различные инфекции, такие как средний отит, абсцессы и пневмонию, хотя она является редкой причиной этих инфекций.
Aggregatibacter actinomycetemcomitans был первоначально выделен Р. Клингером в 1912 году из актиномикотического поражения, и его видовое название означает "встречающийся с актиномицетами". Первоначальное название рода, "Actinobacillus", указывало на звездчатые формы, образуемые колониями на плотных средах. В 2006 году род был переименован в Aggregatibacter, что отражает склонность организмов этого рода к росту в виде дискретных скоплений (агрегатов) в бульонной культуре.
Хотя A. actinomycetemcomitans наиболее известен своей ролью в инфекционном эндокардите, он также является этиологическим агентом заболеваний пародонта. Он специфически связан с локализованным агрессивным пародонтитом, формой пародонтита, поражающей подростков. Эта форма заболевания прогрессирует от появления симптомов до потери зубов в течение нескольких месяцев, а не лет, как при пародонтите у взрослых.
Колонизация вирулентными штаммами A. actinomycetemcomitans наиболее распространена среди лиц африканского происхождения, но относительно редко встречается в большинстве других этнических групп. Среди афроамериканских подростков уровень колонизации может достигать 16,7%, а у части носителей (до 20%) развивается агрессивный пародонтит.

Колонии Aggregatibacter actinomycetemcomitans приобретают звездообразную форму после длительной инкубации.
Cardiobacterium hominis была впервые описана в 1962 году и выделена от пациентов с эндокардитом. Как и другие организмы HACEK, C. hominis обнаруживается в ротоглотке, но редко в желудочно-кишечном тракте. Однако из образцов ротоглотки ее выделяют нечасто, что может быть вызвано чрезмерным ростом других комменсалов. В отличие от других представителей группы HACEK, C. hominis очень редко вовлекается в другие заболевания, кроме эндокардита.
Eikenella corrodens названа в честь М. Эйкена, микробиолога, который впервые обнаружил этот организм. Название вида указывает на то, что он вдавливается (или корродирует) в поверхность плотной агаровой среды. Эта способность связана с наличием пилий, которые могут быть важны для адгезии к тканям хозяина. Она является членом семейства Neisseriaceae, но не может быть выделена на селективных средах для Neisseria spp., таких как агар Тайера-Мартина.
Среди организмов HACEK, Eikenella является более редкой причиной эндокардита, но обладает способностью вызывать заболевание в других локализациях. Наряду с A. actinomycetemcomitans, это один из немногих организмов, связанных с заболеваниями пародонта. Кроме того, E. corrodens ассоциируется с инфекцией после травматической инокуляции из ротовой полости и обнаруживается в 42% абсцессов после укусов человека.
Kingella kingae была открыта и позже названа в честь американского микробиолога Элизабет Кинг. Как и Eikenella, она является членом семейства Neisseriaceae, но в отличие от Eikenella, ее обычно можно выделить на агаре Тейера-Мартина. По сравнению с другими представителями группы HACEK, K. kingae нечасто выделяется при эндокардите. Однако она является важной причиной остеомиелита/септического артрита у детей в возрасте от 6 месяцев до 3 лет. Этот микроорганизм также может передаваться от человека к человеку через дыхательные аэрозоли.
Ранее организмы HACEK связывали с эндокардитом, при котором не удавалось выделить ни одного возбудителя (так называемый "культурально-отрицательный эндокардит"). Это объяснялось медленным ростом в старой рецептуре сред для культивирования крови и приводило к рекомендациям о длительной инкубации (>5 дней) при подозрении на присутствие этих организмов. Однако современные приборы для культивирования крови надежно выявляют организмы HACEK в течение 5-дневного инкубационного периода.
Организмы HACEK могут быть выделены на обычно используемых неселективных средах, часто лучше растут на шоколадном агаре, чем на кровяном агаре. Они не могут быть выделены на селективных средах, предназначенных для энтеритов, таких как агар МакКонки. Идентификация может проводиться с помощью автоматизированных систем, но производительность может быть неоптимальной. Как и для многих других организмов, MALDI-TOF становится потенциальной технологией идентификации для группы HACEK.
Несмотря на стандартизированные методы, тестирование на чувствительность к антибиотикам затруднено, и в 60% случаев эти организмы не растут в панелях разведения в бульоне. Однако тестирование на чувствительность не всегда является необходимым, поскольку основным механизмом резистентности в этой группе является экспрессия одной или нескольких бета-лактамаз, для которых CLSI рекомендует рутинное тестирование с использованием хромогенных субстратов. Резистентность к цефалоспоринам встречается редко, и современные рекомендации по лечению эндокардита предлагают использовать для лечения цефтриаксон.
Группа HACEK включает в себя комменсальные организмы ротоглотки человека. Хотя они наиболее известны тем, что вызывают инфекционный эндокардит, они являются значимыми причинами других заболеваний, включая пародонтит, абсцессы и септический артрит. Представители этой группы известны уже 60-100 лет, но исторически их было трудно культивировать и идентифицировать. Однако современные достижения в области инструментария для культивирования культур крови и масс-спектрометрии MALDI-TOF облегчили культивирование и идентификацию. Тестирование на чувствительность к цефалоспоринам по-прежнему является сложной задачей, но необходимость в нем возникает редко из-за практически универсальной чувствительности к цефалоспоринам.